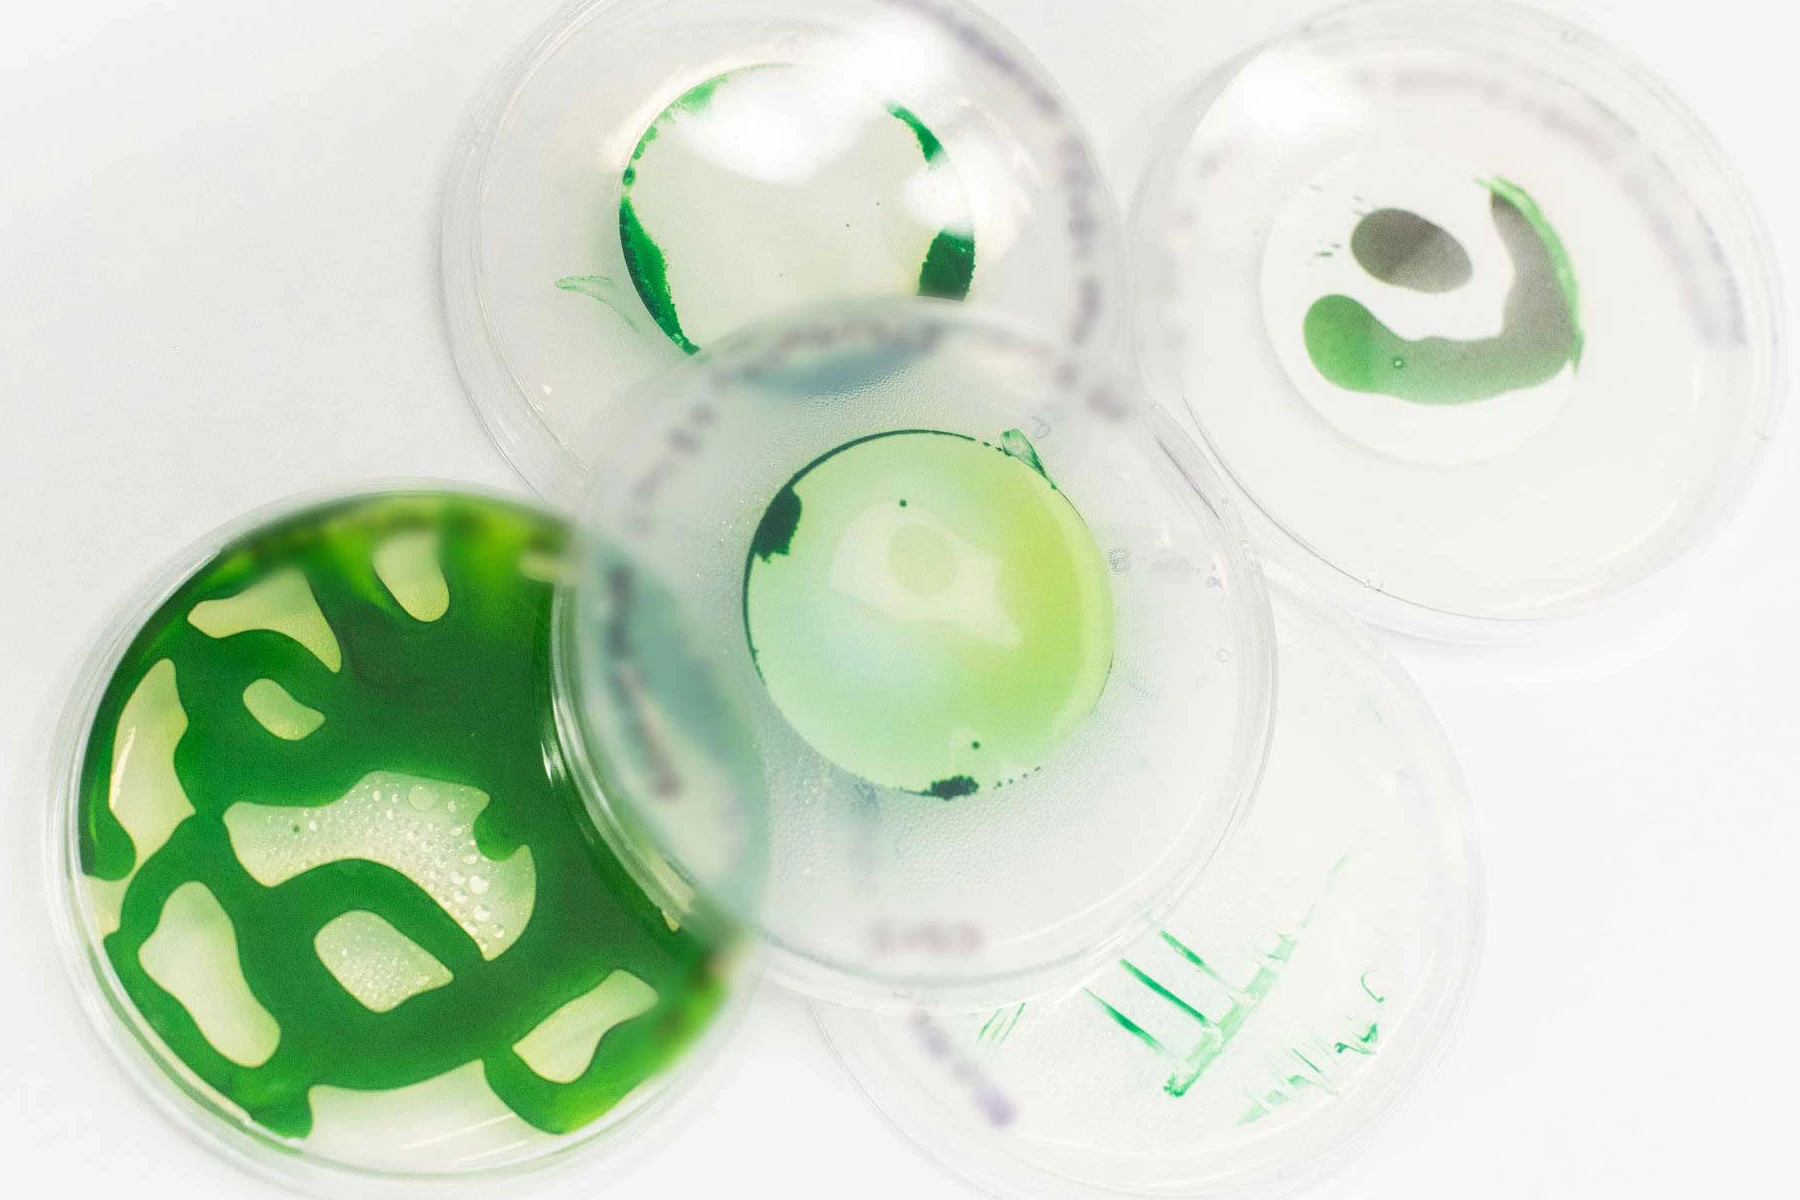
These are not the actual microbes that went down the well. They're not even the same type of microbes. But they are microbes, and sometimes that's all that matters.

Texan company Cemvita is promising clean hydrogen at less than US$1/kg, after testing a fascinating new technique in the lab and the field. The idea is to pump specially developed microbes into depleted oil wells, where they'll eat oil and excrete hydrogen.
Humans have been harnessing tiny single-celled and multicellular organisms to perform work for much longer than we've known what they were. The earliest beers known to history were brewed some 13,000 years ago, making systematic use of a microscopic fungus called yeast, and its habit of eating sugars and starches and excreting carbon dioxide and ethanol. That's about 7,000 years before recorded history was known to history.
Microbes can be incredibly hard workers – Louis Pasteur once described yeast's work on glucose as the equivalent of a 200-pound person chopping two million pounds of wood in two days. But their ability to party is critical as well; in two days under the right conditions, 100 yeast cells can multiply into 400 billion.
Now that humans are beginning to get a handle on genetic engineering, a huge range of other possibilities are opening up. And with the rise of artificial intelligence, it's becoming easier than ever before for scientists to identify which bits of the genetic code are responsible for a microbe's desirable behaviors, and repeat those sections to juice these little creatures up for higher and higher performance.
One company engaged in such work is Cemvita, which is concentrating at present on microbes that feast on hydrocarbons – in particular, crude oil – and ferment them, excreting hydrogen and carbon dioxide. Unfortunately, it's not accurate to describe this release as a belch or a fart – believe me, nothing would make me happier, but in this case the gases simply bubble out through the cell walls without any celebratory audio.
This ties in beautifully with the way oil wells work; they start out at maximum production when they're first tapped, sometimes even squirting out of the earth under pressure. But then things gradually dwindle until it costs more in energy to push or pull the remaining oil out than you can sell it for. So there's plenty of oil left in depleted wells, as well as some handy infrastructure in place at each project. Cemvita wants to turn all these wells into biological hydrogen farms.

So, it presumably stops up the top of the well, before pumping a heap of specially bred microbes down into its murky depths in a stream of recycled water. The microbes go to work, feasting, excreting and multiplying, and Cemvita captures the gases as they exit the top of the well, separating them into hydrogen for processing and sale, and carbon dioxide for sequestration. The company is able to send nutrients and inhibitors down into the well to keep things under control and moving in the right direction.
Cemvita started out in the lab, modifying the micro-organisms genetically, but trying not to go far enough to get them classified as genetically modified.
"We are actively engaging with regulatory agencies (such as EPA) regarding the application of genetically engineered microbes," reads the company's website. "In some cases, since we are only enhancing the natural ability of microorganisms (for example by increasing the copy number of genes that already exist), the microbes are not considered genetically-modified. Regulatory assessment is included as a deliverable for our projects."
The team set its sights on the economic target of hydrogen production at less than US$1/kg, and its oil-munching microbes quickly overshot their performance targets, becoming six and a half times better at their job than Cemvita projected they'd need to be.
From there, it was time to try them out in an actual oil well. Cemvita partnered with an oil production company operating in the Permian basin in West Texas, and stuck a small test load of microbes down into a depleted well. The results: hydrogen levels three times higher than the baseline.
“In a very short time frame," said Zach Broussard, Director of Gold H2 at Cemvita, in a press release, "we moved our microbes from the lab to the field. The hydrogen production in this trial exceeded our expectations. As we continue to use hydrogen producing microbes downhole, we anticipate we can achieve rates that will translate to hydrogen production at $1/kg or less.”

Thus, an oil company's stranded asset becomes an extremely low-effort source of hydrogen – and a very, very cheap one. At less than a dollar a kilogram (2.2 lb) – before subsidies – this could represent some of the world's cheapest H2. And there'll be no lack of feedstock; Cemvita points out that in order to meet the Paris climate goals, some 60% of the world's known oil reserves will need to stay in the ground.
So what are the risks? Well, they're mainly regulatory. Firstly, the company will need to satisfy regulators that its microbes are safe for use, and won't cause unintended environmental consequences.
Secondly, you may have noticed Cemvita can't call its product "green" hydrogen, presumably due to the carbon dioxide that's released as part of the process. Instead, it's calling it "gold" hydrogen, and relying on carbon capture and storage to ensure that its hydrogen is "carbon neutral." This may limit sales as regulations tighten in the long run.
Thirdly, the business model does give us some cause for concern there. Cemvita needs old oil wells to advance its plan, so where it can't buy these wells outright, it'll have to license the technology to, or partner with oil companies to put its microbes to work. The oil companies must be thrilled about the idea – there'd be enough dollar signs spinning in their eyeballs from these long-written-off assets to knock their ten-gallon hats off.
But for this to be good news for the planet, we'll need to trust these oil companies to dutifully capture and permanently store all the carbon dioxide that comes out of their wells. Either that, or we'll need to trust environmental regulators – in Texas, no less, to begin with – to hold these oil companies to their promises. I'm not feeling a ton of trust in my heart of hearts, but hey, that's just me.
Either way, it's a fascinating technology that does seem like it's going to have plenty of money behind it, so it'll be interesting to see how this plays out. Check out a short video below.